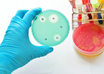

IIT Kharagpur superspecialty hospital to start OPD by year-end
PTI | Oct 22, 2019
Fire at children's hospital in Hyderabad leaves one infant dead, five critical
Partner Content | Oct 21, 2019
Chandigarh: Underdeveloped foetus found in infant girl's abdomen
PTI | Oct 21, 2019
Delhi government, Centre spar over healthcare schemes
IANS | Oct 21, 2019
Long-term asbestos exposure can trigger lung cancer: Experts
IANS | Oct 21, 2019
Smartphone can help patients take pills on time
IANS | Oct 21, 2019
India seeks UN action to combat anti-microbial resistance
IANS | Oct 21, 2019
Delhi Mohalla Clinics cross 300-mark, target 1,000
IANS | Oct 21, 2019
Drinking tea may improve brain health, study suggests
ANI | Oct 21, 2019
Most read this week